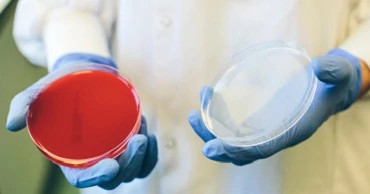
uuid_79e71011-3994-45b7-aca0-4d3fc6f7a2a5_open-petri-dish

Biotech
Developing transformative therapies with small & mid-sized biopharma companies requires a flexible approach
PlayHelping biotech meet critical milestones.
Biotechnology companies are at the epicenter of innovative drug development, with discoveries spanning from genomic medicines to first-in-class immunotherapies. Typically focused on a small portfolio of compounds, or just a single compound, in a particular therapeutic indication, many biotechs lack the full spectrum of resources or infrastructure required to bring these novel therapies to market.
-
1
ICON has the world's largest dedicated biotech division -
8,000
Staff dedicated to biotech customers -
500+
ICON supports over 500 biotech sponsors annually
Our empowered structure enables flexibility and quick decision-making within the global reach one of the world’s biggest and most innovative CROs. Our biotech division of 8,000 people operates with a mindset aligned to small and mid-sized biopharma. Our tailored teams and management understand the different pressures that are faced by biotechs and will engage, collaborate and share ownership in the delivery of your clinical trials.
Case studies
ICON helps biotechs to meet their critical milestones and deliver data and evidence-based results to investors, large pharma partners, regulatory authorities, and other stakeholders with responsiveness, accessibility, and true collaboration.

Early, precise and efficient
The methods and technologies advancing Alzheimer’s and Parkinson’s R&D
In this CNS whitepaper, which includes extracts from our survey of over 120 neurodegenerative therapeutic developers, we examine how innovative methodologies and technologies are being implemented to improve the success rate of clinical trials across a range of neurodegenerative disorders.

ICON survey report
Exploring the application of methods and technologies advancing CNS therapeutic development
Advances in the technologies and methodologies used in CNS clinical trials have played a pivotal role in the development of the first disease-modifying treatments for Alzheimer’s. To better understand trends in adoption and application of these innovative technologies and methodologies, ICON surveyed 129 CNS developers focused on neurodegenerative CNS conditions.

Early phase challenges for biotechs
This whitepaper explores the growing challenges facing biotech during early phase drug development, and how these can be navigated to ensure the best possible outcomes.

De-risking clinical development of precision medicines in oncology
This whitepaper reviews the most pressing challenges and opportunities facing the oncology therapeutic landscape in the emerging era of precision medicine, and reports on how those opportunities and challenges vary by organisational size and region.

Optimising biotech funding whitepaper series
In this two-part whitepaper series on biotech funding, we firstly share insights on how biotechs can secure funding in a highly competitive market, and then shed light on the opportunities available to utilise these funds more effectively and efficiently.

2023 biotech sector survey
Navigating biotech's challenges and embracing a promising tomorrow
Using exclusive data from ICON’s 2023 survey with Citeline, this report presents valuable insights from 133 influential decision-makers within biotech and venture capital organisations from across North America, Europe, and Asia Pacific.

Early engagement and regulatory considerations for biotech
Gain insight into the common questions small and emerging biotech companies face, and the importance of early engagement and regulatory affairs when developing an asset and considering a drug development partner.

Reflections on Bio€quity Europe 2023
Discover ICON’s valuable insights from the 23rd annual Bio€quity Europe conference. As a Regional Host Committee member ICON was uniquely placed to evaluate the key trends set to dominate the biotech funding environment.

Exploring partnership culture and its impact on outsourcing and operational strategy
Partnership culture within the clinical research industry has often been overlooked as a component of a successful outsourcing strategy. However, culture can support, inform, and maintain strategies and operational decision-making.

Procedural and regulatory know-how for China biotechs in the EU
Learn how to navigate the European Medicines Agency registration and regulation procedures and gain access to a potential patient pool of 500 million people.
Biotech insights and media contributions

Media article: Biotech sector survey: From investment confidence to strategic collaborations
In this article from International Biopharmaceutical Industry, Chris Smyth, President of ICON Biotech outlines the findings of the recent ICON biotech sector survey, and explores the role of partnerships and the increasing trend of pharma collaboration, even at the pre-clinical stage.

Media article: Insights and projections shaping the biotech industry
This article summarises the main findings from the biotech sector survey and outlines the key implications for biotech including strategic collaboration, innovation and cost optimisation.

Media article: Shaping the future of novel therapy development
In this article from Citeline, we discuss how drug innovation has the potential to benefit everyone, but it cannot exist in a vacuum. Today’s novel therapies are conceived and developed in a payer-patient- and value-oriented environment, one in which the gap between ambition and uptake is wider than ever.

Blog: Crafting a competitive biotech funding pitch
Biotechs can hone their pitch with the guidelines provided in this blog and through early engagement opportunities with strategic partners.

Blog: Optimising biotech trial designs to stretch your cash runway
Read this blog to learn a few key considerations to help optimise and de-risk your trial design.

Blog: The importance of developing rTPP to build biotech asset value
Discover how Biotechs can build value into their asset by developing a reimbursable Target Product Profile (rTPP).

Blog: Uncertainty to opportunity - Recent trends in the biotech funding environment
In this blog, discover more about how the biotech sector is transforming uncertainty into opportunity.

Blog: Exploring the benefits of biotech partnerships
The biotechnology sector is leading the way in developing innovative therapies that will address the unmet needs of many challenging diseases.

Media article: Moving Beyond a Buzzword
How small- to mid-sized biotechs can adopt patient centricity in their oncology trias.

Media article: Due diligence and beyond
Dr. Sandra Eagle outlines how due diligence has evolved from a discrete standalone technical assessment, to now being an integrated part of the holistic development continuum of an asset.

Media article: Europe’s emerging biotechs
John Macdonald, Vice President, Venture & Financial Alliances, examines the European biotech sector – its expertise and opportunities, and potential for growth.

Media article: Biotech funding
ICON plc has partnered with ALSA Ventures I SCSp, a Europe focused therapeutic venture capital fund, to accelerate early clinical development within the UK and the EU.